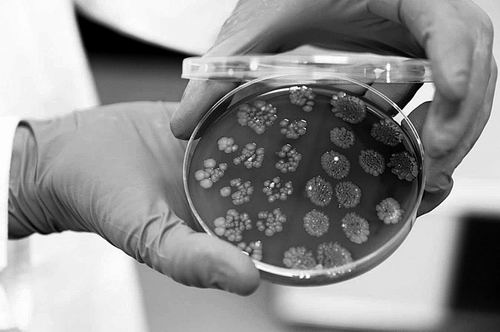

粪便中的细菌可能成为对抗癌症的意外武器。 图片来源:LEWIS HOUGHTON
对治疗无效的癌症患者来说,从药物治疗成功的人身上移植粪便,或许能提高治疗成功的可能性。改变肠道微生物群会对免疫系统产生连锁反应,在一项针对肾癌患者的小型试验中,这种方法似乎有助于稳定肿瘤。1月28日,相关研究成果发表于《自然-医学》。
粪便微生物群移植(FMT)是一种安全的手术,即将一个人的粪便样本移植到另一个人的肠道中,以改善后者的微生物群。该疗法已在英国和美国获批用于治疗复发性耐药艰难梭菌感染,并且对其他疾病,如肠易激综合征也显示出一定疗效。
在治疗癌症时,名为检查点抑制剂的免疫治疗药物通过帮助免疫系统摧毁癌细胞发挥作用,但它们并非对所有人都有效。此前研究表明,对这些药物有反应的人的粪便微生物群,对那些没反应的患者的肠道可能是有益的。“微生物组是宿主免疫力的强大调节器,因此我们假设改变它可以增强免疫力,从而帮助杀死癌细胞。”论文作者、意大利圣心大学的Gianluca Ianiro说。
但此类研究通常集中于黑色素瘤上,并且没有将粪便移植的效果与安慰剂组进行比较。因此,Ianiro和同事招募了45名肾癌患者,他们在过去两个月里开始服用检查点抑制剂帕博利珠单抗和一种阻断肿瘤血液供应的药物阿昔替尼。
然后,研究人员随机将参与者分为两组,一组移植了服药后癌症缓解的人的粪便,另一组接受生理盐水,两者都通过肛门输送到大肠。在首次移植后的3个月和6个月,大多数参与者又以口服的形式接受了两剂指定的治疗药物:粪便微生物群或生理盐水。
在FMT组中,参与者的癌症在首次移植后平均稳定了两年,而安慰剂组则为9个月。更重要的是,FMT组中过半参与者的肿瘤缩小了,而安慰剂组中只有约1/3。
“这为‘肠道微生物组可通过治疗性调控影响免疫疗法效果’提供了强有力的证据。”美国匹兹堡大学的Hassane Zarour说。
FMT究竟如何起作用尚不清楚,但对参与者FMT前后的粪便样本进行的分析表明,引入的一种名为Blautia wexlerae的肠道细菌,能够产生增强抗癌免疫细胞的短链脂肪酸。
FMT似乎也改变了受体肠道中已有的细菌水平。例如,它降低了促进有害炎症的大肠杆菌的水平,提高了Ruminococcus bromii菌株的水平,后者会促进其他产生短链脂肪酸的细菌的生长。
Ianiro表示,还需进一步研究确定粪便中哪些细菌是有益的,这有助于创建用于大规模癌症治疗的人工微生物样本。
(王铄)
相关论文信息:https://doi.org/10.1038/s41591-025-04189-2
《中国科学报》 (2026-02-03 第2版 国际)